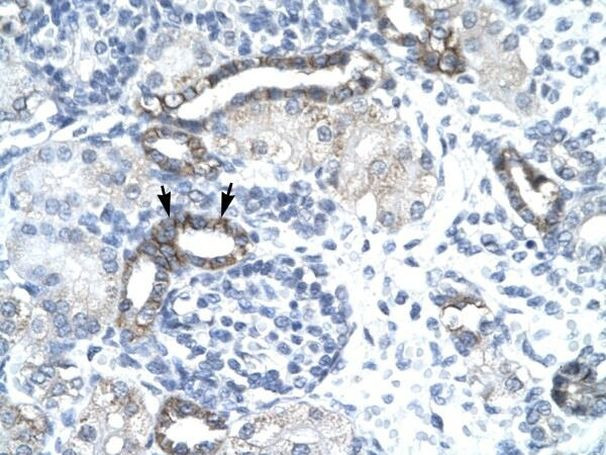
EVX1 Antibody in Immunohistochemistry (Paraffin) (IHC (P))

Search
Invitrogen
EVX1 Polyclonal Antibody
{{$productOrderCtrl.translations['antibody.pdp.commerceCard.promotion.promotions']}}
{{$productOrderCtrl.translations['antibody.pdp.commerceCard.promotion.viewpromo']}}
{{$productOrderCtrl.translations['antibody.pdp.commerceCard.promotion.promocode']}}: {{promo.promoCode}} {{promo.promoTitle}} {{promo.promoDescription}}. {{$productOrderCtrl.translations['antibody.pdp.commerceCard.promotion.learnmore']}}
产品信息
PA1-24495
宿主/亚型
分类
类型
抗原
偶联物
形式
浓度
规格
保存条件
运输条件
RRID
产品详细信息
Predicted reactivity: Cow: 100%; Dog: 100%; Guinea Pig: 100%; Mouse: 100%; Rabbit: 100%; Rat: 100%.
Store product as a concentrated solution. Centrifuge briefly prior to opening the vial.
靶标信息
EVX1 is a member of the vertebrate eve-related homeo box family. This protein acts as a transcriptional repressor. A similar protein in mice is critical for early embryogenesis.
仅用于科研。不用于诊断过程。未经明确授权不得转售。